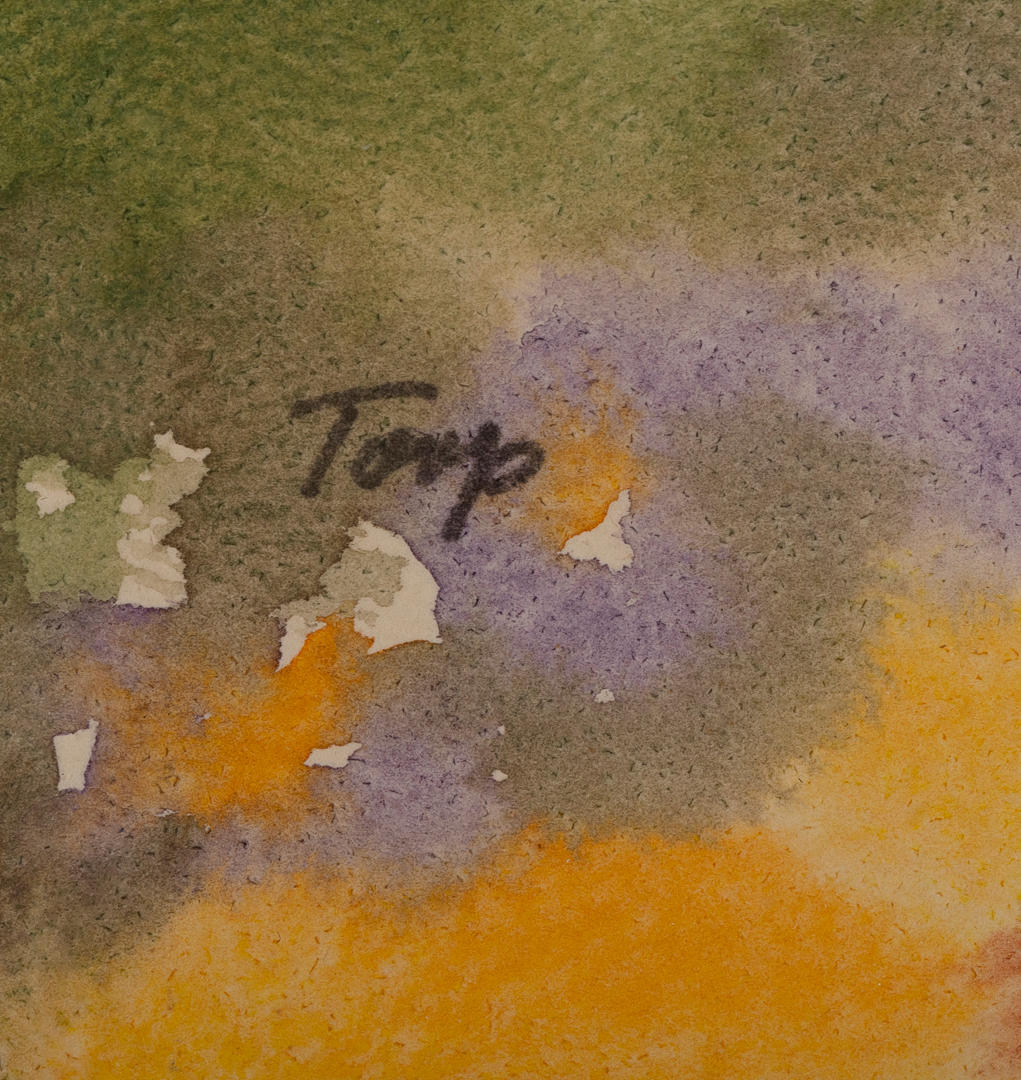

Här är dom olika typerna av cookies som används på Auctionet.com, med en beskrivning om vad dom gör. Du kan välja vilka typer av cookies du ger medgivande till.
Du kan läsa mer i vår integritetspolicy.
Alltid aktiva
Dessa cookies är nödvändiga för att Auctionet ska fungera korrekt.
Auctionet sparar information för att identifiera dig under ditt besök. Detta används till exempel för att hålla dig inloggad.
Auctionet sparar dina aktuella inställningar för cookies.
Cookies som används för att anpassa innehåll och funktioner på Auctionet.
Auctionet sparar din besökshistorik så att du enkelt kan hitta tillbaka till föremål du har besökt.
Auctionet sparar information om vilket språk och vilken valuta som ska användas.
Dessa cookies används för att utveckla och förbättra Auctionet genom att samla in statistik.
Auctionet analyserar användarbeteenden för att förbättra tjänsten.
Auctionet testar regelbundet nya funktioner och förbättringar.
Dessa cookies används för att visa relevant innehåll på andra webbplatser.
Auctionet analyserar hur du använder tjänsten för att kunna tipsa dig om relevant innehåll på andra webbplatser.